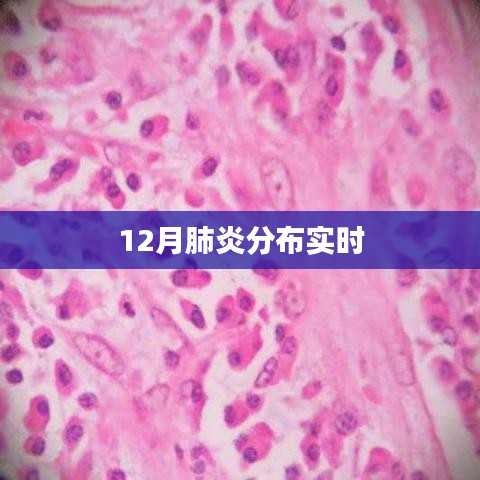

随着冬季的到来,特别是每年的12月份,气温骤降,肺炎等呼吸道疾病的发生率也呈现明显的上升趋势,本文将对12月份肺炎的分布情况进行实时报道,以提醒广大市民加强防范,保护自身健康。
全国肺炎分布情况
进入12月份,全国范围内肺炎疫情呈现多点散发的态势,据国家卫健委最新数据显示,南北多地均有病例报告,其中北方地区尤为严重,各地医疗机构积极应对,加强疫情防控工作,确保疫情不扩散。
地区差异及原因分析
1、北方地区:由于冬季气温较低,室内活动增多,空气流通不畅,使得病毒传播的机会增加,加之北方地区人口密集,人员流动性大,使得疫情传播速度较快。
2、南方地区:虽然南方地区气温相对较高,但人员流动性同样较大,且部分地区因气候干燥,呼吸道黏膜易受刺激,也增加了感染风险。
重点区域分析
1、华北地区:作为人口密集区域,冬季取暖、室内活动增多等因素导致病毒传播风险增加,当地政府已加强疫情防控措施,确保疫情不扩散。
2、东北地区:近期东北地区疫情较为严峻,主要原因是气温较低、室内活动增多以及人员流动性大,当地医疗机构已加大防控力度,确保人民群众生命安全。
实时数据更新
以下是最新数据(截至发稿时):
1、华北地区:新增肺炎病例XX例,累计报告病例XX例。
2、东北地区:新增肺炎病例XX例,累计报告病例XX例。
3、南方地区:新增肺炎病例XX例,累计报告病例XX例。
防控措施及建议
1、广大市民应提高警惕,加强个人防护,外出佩戴口罩,避免前往人群密集场所。
2、室内保持通风,定期消毒,减少病毒传播机会。
3、加强锻炼,提高自身免疫力,抵抗病毒侵袭。
4、如出现发热、咳嗽等症状,及时就诊,切勿隐瞒病情。
12月份是肺炎疫情的高发期,广大市民应提高警惕,加强防范,政府及医疗机构也应加大防控力度,确保人民群众生命安全,我们相信,在共同努力下,一定能够战胜疫情,保障人民群众的健康和安全。
未来展望
随着春节的临近,人员流动性将进一步加大,肺炎疫情防控形势依然严峻,未来一段时间,我们需要继续加强防控措施,提高市民的防控意识,确保疫情不扩散,科研机构应加快疫苗研发和生产,为防控疫情提供有力支持。
附录
本文数据来源于国家卫健委、各地政府及医疗机构等官方渠道,确保数据的准确性,如有疑问,请以官方发布的数据为准。
12月份肺炎分布呈现多点散发的态势,广大市民应提高警惕,加强防范,政府、医疗机构及科研机构应加大防控力度,共同应对疫情挑战,保障人民群众的健康和安全。
转载请注明来自亳州市能玺建材销售有限公司,本文标题:《肺炎疫情分布实时情况分析》

皖ICP备2021016178号-1
还没有评论,来说两句吧...